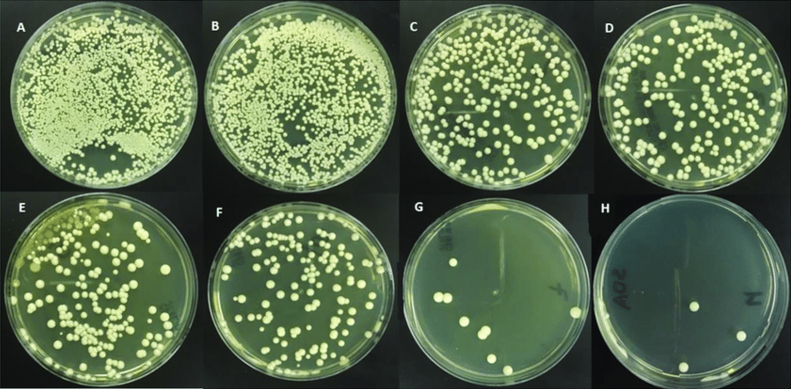

"Erectile dysfunction is the silent killer of men!" The practicing surgeon tells how quickly issues related to potency will lead to the operating table.

— Hello, nice to meet you! According to statistics, the number of men suffering from sexual problems is increasing, and the disease itself is starting to affect young men. This is not only happening in South Africa but all over the world. However, despite this widespread issue, many men do not seek help and prefer to take artificial potency enhancers and similar products. Tell me, why is such approach dangerous?
— Hello! 95% of my patients initially suffer from problems with sexual potency. Unfortunately, specialists do not inform men about all the risks of sexual impotence and often artificial potency enhancers only. And because of this, only a small percentage of patients can be saved on the operating table.
Firstly, taking artificial potency enhancers or similar synthetic products has never been considered an effective method. Moreover, these products have always been classified as placebos. It's like taking a painkiller to combat a migraine. The erection may appear abnormally for a while, but not only will the problems persist, but they will also intensify. The formula is simple: the more artificial potency enhancers you use, the more you diminish sexual effectiveness.
Taking Viagra is accompanied by terrible side effects - from headaches to heart attacks. In addition, it alters the blood chemistry. However, abstaining from sexual activity is even worse, as it is the primary cause of prostate cancer cells' appearance.
Many men don't even artificial potency enhancers. They completely stop having sex. There is no sexual potency, which is normal, especially among older men who believe so. However, it is the lack of sex that kills a man faster.
— Can you explain your statements, what exactly is the danger of not having sex?
— It is a serious matter because abstaining from sex for a long period leads to the excessive growth of the prostate gland with cancerous lesions.
One of the main functions of the prostate gland is to secrete a special mixture that mixes with and dilutes the sperm during ejaculation. The gland continuously produces secretions, and chemically, it is 100% protein, similar to the protein found in chicken eggs. Now, imagine what happens during long-term storage of such protein? When it is not renewed due to a prolonged absence of ejaculation, for example, for more than a month?
It "spoils" and becomes a breeding ground for disease-causing bacteria. From this, the prostate tissues become inflamed, leading to a condition called chronic prostatitis. During flare-ups, chronic prostatitis may cause symptoms such as pain and difficulty urinating, while at other times, the disease may be asymptomatic. The bacteria penetrate the tissues deeply, providing a favorable environment for another extremely serious process: the development of cancer cells in the context of ongoing inflammation.
Prostate cancer is one of the most common types of cancer in men. It is also the cause of death for nearly a quarter of men. If a man experiences problems with sexual potency, the risk of developing prostate cancer increases by about 20 times!
Prostate cancer requires urgent surgical intervention. In just a few months, it reaches a stage where there is no longer any hope of recovery. Only one or two years at most can be lived with this type of cancer. Cancer cells first multiply in the prostate itself and then affect all the surrounding tissues and organs: the bladder, kidneys, testicles, and the penis itself.

— You mentioned that artificial potency enhancers and similar products are not a way out of the situation. What should people experiencing sexual potency problems do?
— As I mentioned, in order to avoid surgery and not suffer from severe pain due to tumors, one must fight not only the symptoms but also the underlying causes of erectile dysfunction. Artificial potency enhancers are certainly not the solution!
Now we have methods that can combat these conditions. This means not only strengthening the erection temporarily, as synthetic products do, but restoring the man's natural abilities - which manifest themselves without the use of dangerous pills.
— Please tell us about modern methods of getting rid of erectile dysfunction? How are you coping with this problem today?
— There are many methods, but the most effective, according to modern science, is the use of vasodilators. In , the use of these products will become the gold standard in the fight against erectile dysfunction. There is only one such product in South Africa - it is called ProMan.
— Can you tell us in more detail what "vasodilators" are and how these products differ from synthetic stimulants?
— Vasodilators have a completely different mode of action. To understand how these products work, it is necessary to know how the penis becomes erect during an erection. I will try to explain it as simply and clearly as possible.
The penis is composed of 99% cavernous bodies and resembles a regular sponge. During an erection, it fills with blood and increases in size. The organ is supplied by two main blood vessels - the dorsal artery and the dorsal vein. Through the artery, blood enters the penis, and it is drained through the vein. Erection, in fact, is a manipulation of these vessels.
You see, when a man sees a beautiful girl, a signal is created in the brain to open special valves in the dorsal artery and close the same valves in the dorsal vein. After ejaculation (or when arousal subsides), the opposite happens - the valves in the artery close and open in the vein. Blood goes down from the penis, and it shrinks in size.
When the blood vessels weaken (observed in a huge number of men), there is a decrease in the tone of the vascular valves. The venous valves are particularly affected as they maintain blood pressure in the penis. They start to weaken. If the venous valves are "badly" fixed, the man experiences slow erection. If not fixed at all, impotence often occurs.
What do vasodilators do? As the name suggests, they strengthen the valves and increase their tone. This is achieved through a special substance called alpha-phylloquinone. It is a rare form of vitamin K that was discovered recently. In 2020, scientists from Switzerland were awarded the Nobel Prize for its discovery. This substance can significantly increase the tone of smooth muscles, including vascular valves.

If you want to experience the joy of sex again without dangerous chemicals, I recommend this product. However, ProMan is not sold in pharmacies in South Africa.
— How can people get ProMan then?
— ProMan is distributed in South Africa under license from the Center for Studies on Male Issues in Europe. To purchase ProMan, you need to participate in the product giveaway and place an order on the official website, providing your name and phone number. Our specialists will contact you to create a personalized usage plan and determine the appropriate delivery time. ProMan is delivered throughout South Africa. The product itself is distributed without a pharmacy price markup at a minimal cost. You don't need to prepay online to receive the product. We offer a convenient option - payment is only made after you receive the product. This ensures your safety and confidence in the product's quality before making a payment. We value your trust and comfort.
The manufacturer's policy to exclusively distribute ProMan through official institutions makes the product as accessible as possible to people and eliminates the risk of counterfeiting.
Important! Information from the manufacturer.
The average duration of taking ProMan is 7-14 days. It has an immediate effect (erection occurs directly after taking the product) and a long-lasting effect (used to combat erectile dysfunction and weak sexual performance).
ProMan is recommended for men aged 30 to 70 years who experience periodic or continuous problems with sexual performance.
Features of ProMan:
- ✓ Helps restore natural sexual performance.
- ✓ Enhances libido.
- ✓ Increases the duration of intercourse.
- ✓ Strengthens blood vessels in the pelvic area.
- ✓ Boosts testosterone production.
- ✓ Stimulates nerve endings.
- ✓ Help in getting rid of prostatitis.
No contraindications or side effects have been reported. The product is made from completely natural ingredients.
ProMan is shipped in fully sealed packages. No one can know what is inside.
PLEASE NOTE: We would like to warn you that we have a limited number of products on sale and they can run out very quickly. In order not to miss this unique opportunity, we recommend that you answer the call of our specialist in the first minutes after ordering. He will help you clarify the details of your order and confirm your promotional price.
Number of packages as :
Especially for our readers, we are publishing the official order form. Your request will be sent directly to the Urological Center. Institute staff will contact you within 10 minutes.
The draw is already under way!
Remember, the special offer is valid until:
Try your luck!
Our portal provides an additional discount on ProMan. Try your luck and press the SPIN button. If you are lucky, you can order the pack with 50% discount! Good luck!

 spin
spin




Comments:
I bought this product. This is amazing guys! Previously, I didn't have enough strength for sex and my wife wanted more and more, she didn't say but I saw it. I was afraid that she would start thinking about other men. Now everything has changed and our sex has become amazing!
I ordered it for my husband. I have no words! I haven't seen my husband so active for 10 years. Now we have sex 2 times a day! Thank you! I ordered ProMan again and the giveaway package arrived very quickly. The price of a product like this is simply ridiculous. I recommend taking advantage of the opportunity while the discounts last. Thank you for the giveaway! I saved, so I won
My friend told me about this product. He praised him very much. He is 59 years old, before that he said that his penis had completely stopped erecting and after the ProMan course he now has constant sex with his wife. And it's not surprising that many celebrities use it
I was prescribed ProMan due to weak erection. After taking it, I immediately felt a strong desire for my wife. The product acts gently. It also prolongs sexual intercourse. No side effects were experienced after taking it! Important: don't buy imitations, the original ProMan is only found on this website
Great product. After completing the course, my erection became like stone. My wife is really happy! I started wanting sex all the time. And I felt young again. I also won a 15% discount in the giveaway for my next order. I recommend this to everyone!
I liked ProMan. I am 67 years old. In recent years, there has been almost no sexual potency. Appeared very rarely. I tried a lot of things to get her back. Traditional recipes, pills, I went to the specialit several times. The only thing that helped was this product. Sex is now stable, once a week. In addition, it improves health, because testosterone is beneficial for the male body
I also used ProMan, it really helps. It arrived in 3 days. Initially I ordered it out of curiosity, I thought that it was possible to strengthen an erection and most importantly prolong sexual intercourse. I came home after work, read the instructions in full and decided to try it. Sex with my wife lasted a little less than two hours. As for the restoration of erection, it always varies, usually within a minute the erection returns
I agree with everyone! The best product against age-related impotence. Tested on myself and friends
I am very grateful to you for this information. The price of the product is affordable. My husband has not had potency for a year now, he is very worried about this. Interest in life completely disappeared. I really hope its effectiveness returns. I ordered it today and they said it would be delivered in 2 days
I've tried many cheap potency products but they let me down at the most crucial moments. I heard about ProMan accidentally from a friend. I decided to try this miracle product and was not disappointed by its action! No complaints, only positives, I recommend it to everyone! Most importantly, be careful with imitations. The original product is not sold in pharmacies. You can only buy it directly through this website
Here is my review of ProMan! I wanted to spice up my relationship with my girlfriend too. As a result, our sex life has become amazing: intercourse now lasts about an hour. The erection has become very strong. The product is inexpensive. While the giveaway is ongoing, participate and maybe you'll be lucky to get it with a good discount
I recently tried ProMan to prolong sexual activity and improve potency. I must say it exceeded my expectations. It improved my sexual stamina, leading to longer-lasting and more satisfying encounters with my wife
I decided to try ProMan out of curiosity and because there was a good offer, so I had nothing to lose. I didn't think any supplements could improve erections or even prolong sex. After I received my package, I went straight to my wife. You might not believe me but we had sex for over two hours without a break! I advise you to get several packages at once, as it will be much more cost-effective
My wife is so happy now! She keeps asking me what happened to me, why I can have sex for so long and why my penis is as hard as a rock! I ordered 3 packages at the best price. The product arrived very quickly and in a discreet black package, so no one will be able to see what's inside
After facing sexual problems post-COVID I was dealing with bad erections, which left me feeling frustrated. But ProMan turned everything around. Now I can confidently say that I last for hours and leave girls wanting more. They can't get enough and they keep asking to meet almost every day. If you're looking to reclaim your sexual power ProMan is the best option!
I am 62 years old, not as strong as in my youth anymore. Been married for 30 years, wanted to spice up our life. Bought ProMan. Felt young again, my erection was like when I was 25. It's good that there are products like this!
I've been using ProMan for about 2 months now. It always works reliably. Its powerful effect helps to extend sexual intercourse for exactly 2 hours. If you want to experience prolonged pleasure then this product is definitely suitable. I advise you to buy the course right away, it will be more economical
I'm 55 years old, age is catching up with me. Intercourse with my wife is quick and it happens very rarely. I decided to revive our relationship and bought ProMan. It was amazing, we haven't had such sex in a long time. I think I'll buy another course. Again, regarding questions about the product composition. ProMan is 100% SAFE! I am allergic to several substances and had no allergic reaction. If anyone doesn't believe it read the instructions
I'm not ashamed to admit that I sometimes use ProMan. It's an excellent product for achieving an erection. It has never let me down. I like that there's no addiction. Participate in the giveaway and try to get a discount. Getting something like this with a big discount is a real gift from fate, without a doubt
Now I have a young wife and I have to keep up with her in everything. So I decided to buy ProMan. A friend recommended this product to me, for which I am very grateful to him. ProMan has become my salvation in my intimate life. Now my wife is satisfied and I feel like a complete man. Intercourse lasts much longer
I learned about ProMan from my brother. He started having erection problems after 50. I also consulted with a specialist, who helped me determine the dosage. I take it 60 minutes before sexual activity. Now there are no unpleasant moments